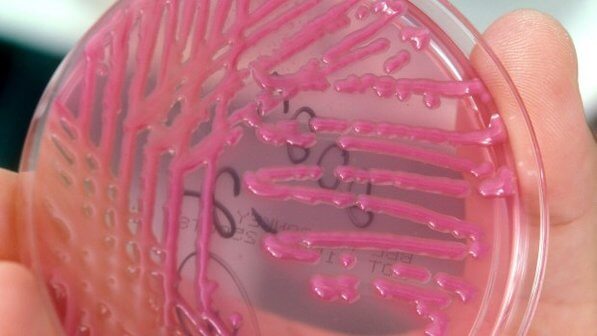
Клебсиелла у грудничка в моче

Наряду с золотистым стафилококком, клебсиелла у грудничка, к сожалению, тоже не редкость. Возвращается из роддома малыш зачастую уже больным, либо к заражению приводит несоблюдение правил гигиены дома. В любом случае родителям следует знать, что это за инфекция и как ее лечить, чтобы в случае необходимости быть осведомленными в данном вопросе.
Клебсиеллез – детское заболевание, которое требует обязательного врачебного вмешательства
Что такое клебсиелла и чем она опасна?
В различных органах человека (носоглотке, кишечнике, слизистых оболочках) существует собственная микрофлора. Это понятие включает в себя определенное соотношение полезных микроорганизмов и условно-патогенных микробов. К последним относят: стрептококки, золотистый стафилококк, хеликобактер пилори и клебсиеллу в том числе.
При воздействии на организм негативных факторов или при попадании бактерий извне, один или несколько видов микроорганизмов начинают активно размножаться, подавляя при этом остальные виды бактерий. В таком случае равновесие микрофлоры нарушается, и условно-патогенные микробы становятся патогенными.
В случаях, когда меры по восстановлению баланса не приняты вовремя, болезнь способна вызвать тяжелые последствия:
- менингит (поражение оболочек головного мозга);
- сепсис (заражение крови);
- отек легких (выход жидкости из сосудов в бронхи и альвеолы);
- токсический гепатит (поражение печени).
В группе повышенного риска находятся новорожденные, особенно недоношенные и дети с низким иммунным статусом. Груднички, находящиеся на искусственном вскармливании, подвержены высокому риску развития заболевания, так как лишены возможности получать вместе с материнским молоком иммунные клетки.
Возбудители клебсиеллеза и их классификация
Клебсиелла – грамотрицательная факультативно-анаэробная (т. е. способная к существованию как при наличии, так и при отсутствии кислорода) бактерия семейства энтеробактерий. Внешне напоминает толстую эллипсовидную палочку. Клебсиеллы имеют защитные капсулы, что делает их довольно устойчивыми к окружающей среде. Бактерии способны в течение длительного времени существовать на предметах, игрушках, в воде и почве. В молочной продукции палочки выживают даже при пониженной температуре (в холодильнике). Температура выше 65° для них губительна, в течение часа клебсиеллы погибают.
Последняя классификация выделяет следующие виды klebsiella:
- aerogenes;
- granulomatis;
- michiganensis;
- milletis;
- raoultella (planticola, ornithinolytica, terrigena);
- quasipneumoniae;
- senegalensis;
- steroids;
- oxytoca;
- pneumoniae.
Внешний вид клебсиеллы
Несмотря на такое разнообразие микроорганизмов, наибольшую опасность для детей представляют два последних вида. Часто бактерия присоединяется к уже обосновавшемуся в кишечнике грудничка золотистому стафилококку (рекомендуем прочитать: как лечится стафилококк у грудничка и фото заболевания).
Характерные симптомы
В зависимости от типа бактерии, поразившей кишечник ребенка, будет различаться клиническая картина. Клебсиелла пневмоника дает осложнения на легкие ребенка, вызывая пневмонию, тогда как окситока вызывает острую кишечную инфекцию. Новорожденные тяжело переносят оба этих заболевания и нуждаются в экстренной госпитализации.
Основные проявления со стороны легких
Заболевание носит острый характер. Симптомы пневмонии, вызванной клебсиеллой, схожи с менингококковой инфекцией:
- внезапная лихорадка 39-39,5 С°;
- сильный кашель с мокротой, содержащей прожилки крови;
- возможна рвота;
- хрипы в легких;
- затрудненное дыхание.
Заражение бактерией сразу же проявляется ухудшением состояния ребенка, но точный диагноз можно поставить только после сдачи лабораторных анализов
По симптоматике видно, что она не имеет каких-либо отличительных черт, по которым можно было бы сразу дифференцировать заболевание. К тому же сила проявления тех или иных симптомов напрямую связана с возрастом и иммунитетом ребенка. Без обследований диагноз не сможет поставить даже врач.
Проявления со стороны ЖКТ
Клиническая картина схожа с другими кишечными расстройствами:
- потеря аппетита;
- лихорадка;
- многократная рвота;
- частый слизистый стул желто-зеленого цвета;
- землистый цвет кожи;
- резкая потеря в весе (особенно у грудничков);
- обезвоживание организма.
Определить по данным симптомам, что именно вызвало гастроэнтерит, невозможно. Для этого необходимо сдать анализы.
Диагностика
Постановка корректного диагноза и подбор эффективной терапии под силу только врачу и невозможен без сдачи анализов. Независимо от проявлений при подозрении на клебсиеллу сдают: общий анализ крови, кала, мочи, копрограмму. В моче бактерия может не высеиваться. При симптомах пневмонии обследуют мокроту больного.
Клебсиелла пневмония в кале у новорожденного
Клебсиелла пневмония является нормальной составляющей микрофлоры кишечника, и ее выявление не всегда указывает на заболевание. Норма в 1 г кала для грудничка составляет 10 в 6 степени. При таком результате анализа лечение не требуется. При показателе 10 в 7 степени на грамм ставят диагноз клебсиеллезная пневмония и назначают терапию.
Читайте также:
Очаговая пневмония симптомы у детей
Клебсиелла окситока в кале у малыша
Обнаружение палочки также не всегда является поводом для беспокойства. Лечение клебсиеллы окситока не требуется, если ее количество в кале не превышает 10 в 6 степени. Количество бактерий 10 в 8 степени указывает на гастроэнтерит, вызванный окситокой. Бактерия, обнаруженная в моче, может говорить о поражении мочеполовой системы.
Посев бактерий при диагностировании больного
Методы лечения
Основываясь на результатах анализов и анамнезе пациента, врач подбирает лечение. В зависимости от характера поражения кишечника и клинических проявлений решается вопрос о применении антибиотиков. Терапия должна быть направлена не только на подавление клебсиеллы, но и на восстановление равновесия микрофлоры кишечника.
Применение антибиотиков
Детей стараются лечить от палочки без применения антибактериальной терапии. Однако существуют показания к приему антибиотиков:
- осложненные формы клебсиеллеза (например, когда он сочетается с золотистым стафилококком и другими бактериями) (см. также: основные признаки золотистого стафилококка у детей);
- длительное течение, не поддающееся альтернативному лечению;
- плохая клиническая картина, высокий риск развития осложнений, когда нет времени на применение более щадящих средств.
В таких случаях для лечения применяют цефалоспорины 3-4 поколения: Цефтриаксон, Цефотаксим, Супракс. Следует отметить, что бактерия устойчива к пенициллиновой и оксациллиновой группам.
Антибиотики весьма эффективны в лечении клебсиеллеза, однако их применение убивает в кишечнике в том числе и полезную флору. После терапии необходимо медикаментозно восстанавливать равновесие микрофлоры.
Лечение бактериофагами
Если у малыша выявлена клебсиелла, но при этом он хорошо себя чувствует, идеальным средством понижения уровня бактерий в кишечнике будет бактериофаг. Так называют специальные вирусы, которые, в отличие от антибиотика, воздействуют только на палочку клебсиеллы (для каждого микроба свой бактериофаг), не нанося вреда остальным микроорганизмам и не нарушая равновесия в ЖКТ.
Проведение регидратации
Организм взрослого человека состоит на 75% из воды, а новорожденного аж на 90%. Именно поэтому нам так важно вовремя пополнять запасы жидкости. Когда у ребенка кишечная инфекция, он сильно теряет в весе. К тому же происходит обезвоживание организма. Очень важно не допускать критического состояния, поскольку сложно потом провести регидратацию. Так называют восполнение водных запасов организма.
Вместе с жидким стулом и рвотными массами выходит не только жидкость, но и минеральные запасы солей. При первых проявлениях гастроэнтерита, не дожидаясь истощения водных запасов, необходимо начать отпаивать малыша (рекомендуем прочитать: гастроэнтерит у детей: симптомы и лечение).
Одним из самых распространенных препаратов для регидратации является Регидрон. Представляет собой порошок, расфасованный в пакетики. Содержимое 1 пакета разводят в литре теплой воды и дают ребенку. Полученный раствор содержит все необходимые соли и минералы. Минусом является неприятный вкус.
Специально для грудничков существуют аналоги Регидрона со вкусовыми добавками. Наиболее популярные из них:
- Хумана Электролит;
- Гастролит.
Эти препараты дополнительно содержат в своем составе фенхель, способствующий снятию спазма и вздутия живота. Если под рукой не оказалось специализированных препаратов, восстановить баланс поможет минеральная вода. Допускается также самостоятельное приготовление раствора – для этого в 1 литре воды разводят 18 г сахара и 3 г соли.
Главное правило регидратации – отпаивать больного необходимо маленькими порциями. В зависимости от возраста разовая доза составляет 1-2 чайные ложки, иначе поступающая жидкость только вызовет новый приступ рвоты. В запущенных случаях в условиях стационара регидратацию проводят при помощи капельниц.
Использование пробиотиков
Пробиотики могут быть использованы в следующих случаях:
- Как самостоятельная терапия при лечении клебсиеллы. Речь идет о слабых формах недуга, когда малыша практически ничего не беспокоит, а анализ показал пограничные значения.
- В качестве восстанавливающих препаратов. После лечения, особенно антибиотиками, необходимо заселить кишечник полезными микроорганизмами.
Для этих целей широко применяются: Бифиформ малыш, Примадофилус бейби, Бифидус. Препараты выпускаются в виде порошков, их удобно добавлять в молоко или воду. Пробиотики помогут быстро восстановить работу ЖКТ, избавив кроху от проблем с животиком.
Врач-педиатр 2 категории, аллерголог-иммунолог, окончила БГМУ Федерального агентства по здравоохранению и социальному развитию. Подробнее »
Клебсиелла (Klebsiella) – условно патогенные бактерии, живущие и размножающиеся без наличия кислорода. В организме человека находятся в виде палочек, вне его –- в капсулах. В капсулах выживаемость их большая.
Читайте также:
Очень тяжелое дыхание при пневмонии
Из-за их большой устойчивости к противобактериальным препаратам всемирная организация здравоохранения отнесла в 2017 году бактерии клебсиеллы к очень опасным. Особую угрозу представляет клебсиелла у грудничка.
Что же делать в такой ситуации ? Для начала советуем почитать эту статью. В данной статье подробно описываются методы борьбы с паразитами. Также рекомендуем обратиться к специалисту. Читать статью >>>
Клебсиелла
Мнение доктора Комаровского
При нормальных условиях клебсиелла находится в организме ребенка, но ничем себя не проявляет. Она является абсолютно безопасной, живет в организме любого здорового ребенка и взрослого.
Как только произошел сбой в иммунной системе, например, после применения антибактериальных препаратов, нормальная флора кишечника изменилась.
Бифидобактерии и другие полезные бактерии стали подавленными, тормозить интенсивный рост клебсиелл некому, вот и начался их интенсивный рост. А вот это уже угроза жизни маленького ребенка. Опасность заключается в их сильном токсическом воздействии на организм грудничков.
Что может спровоцировать рост и запуск развития
- Переход с грудного вскармливания к искусственному.
- Нарушение санитарного режима и гигиены.
Симптомы и проявление
По месту локализации условно можно разделить бактерии на основные виды:
- клебсиеллезная пневмония;
- клебсиеллезная кишечная инфекция.
Клебсиеллезная пневмония
Клебсиеллезная пневмония очень опасное заболевание для грудных детей и новорожденных. При неправильном или несвоевременном лечении болезнь чревата своими многочисленными осложнениями.
Основные симптомы
- высокая температура (до 40 градусов);
- вялость, слабость;
- сильный кашель (вначале сухой, затем с тягучей слизью, возможно с примесью крови).
При запущенных формах болезни возможен летальный исход.
Но такие, ярко выраженные симптомы, не всегда присутствуют у грудного ребенка. Родителей должно насторожить, если у грудничка появился жидкий стул, вялость. Возможно отсутствие повышенной температуры, но появляется кашель, симптомы бронхита.
У грудных детей процесс нарастания заболевания идет лавинообразно: от легкого недомогания до серьезных осложнений может пройти всего несколько часов.
При первых симптомах болезни необходимо срочно обратиться к врачу!
Клебсиелла в кишечнике у грудничка
Клебсиеллезная кишечная инфекция
Правильный диагноз не всегда удается сразу поставить, поскольку симптоматика схожа на заболевания энтеритом, энтероколитом и другими острыми заболеваниями ЖКТ.
Начало болезни бурное:
- высокая температура тела ребенка (доходит до отметки 39 C );
- рвота до 8 раз в сутки;
- сильный понос (до 15 -20 раз);
- пена и кровь в кале;
- изменяется цвет кала на зеленый;
- гнилостный запах фекалий;
- живот болезненный;
- отказ от еды;
- состояние ребенка ухудшается очень быстро;
- быстро наступает обезвоживание.
При этих грозных симптомах ребенку нужна срочная госпитализация! Для грудного ребенка это очень опасно!
В случае, если на лицо не все перечисленные симптомы, а только некоторые, нужна консультация врача.
Откуда берется
Бактерии клебсиеллы находятся в воде, на поверхности овощей, фруктов, в почве и т.д. Это старейший житель нашей планеты и выживаемость его очень высока.
Заразить грудничка можно в роддоме через оборудование, от инфицированных больных, от нестерильных бутылочек с прикормом, от грязных рук мамы и т.д.
Животные могут переносить бациллы на своей шерсти, поэтому их стоит убрать из квартиры после рождения ребенка.
Клебсиелла у грудничка в кале
При случайном обнаружении клебсиелл в кале у грудничка, паниковать не стоит. Это нормальное явление. Необходимо следить за состоянием малыша. Если он здоровый, хорошо кушает, не капризничает, наличие этих бактерий не является поводом для беспокойства. Бороться с этими бактериями не стоит.
Клебсиелла у грудничка в моче
Моча у грудничков практически стерильна. Наличие клебсиелл в моче не всегда свидетельствует о заболевании. У грудничков очень трудно собрать чистую мочу, поэтому необходимо анализы сдать трижды.
Вероятность неправильного сбора таким образом отсеется. Если при последующих сдачах анализа клебсиеллы снова высеваются в большом количестве, можно предполагать наличие заболевания.
Для уточнения диагноза у новорожденных или грудных детей, осуществляют урологическое обследование.
Нормы
Для диагностики заражения клебсиеллой используют любые выделения ребенка: кал, мочу, слизь из носоглотки и т.д Основным методом определения бактерий является бак посев кала.
При обнаружении в 1 г испражнений более 106 микробных представителей, диагностируют клебсиеллез. Как правило, среднее значение klebsiella в кале составляет 10 4 и является нормой.
Если клебсиелла обнаруживается в моче и присутствуют клинические проявления заболевания, то у ребенка острая инфекция мочевыводящих путей.
Читайте также:
Какие признаки пневмонии как проявляется
Нужно ли лечить
Если малыш чувствует себя хорошо, набирает вес, развивается по возрасту, не имеет никаких симптомов болезней, но в кале обнаружили клебсиеллы, не волнуйтесь и не спишите пичкать ребенка лекарством. Сдайте анализы в другой лаборатории несколько раз, если вас это сильно беспокоит.
При нарастании титров, обратитесь к специалисту.
Как лечить
Новорожденных детей и детей с сильной интоксикацией лечат в стационаре.
Общая схема лечения направлена на:
- Назначение кишечных антисептиков (Уроксолин, Фуразолидон).
- Назначение пробиотиков (Бифиформ, Лактовит).
- Применение ферментов (Фестал, Панкреатин).
- Использование бактериофагов (Бактериофаг Клебсиелл).
Примерная схема лечения при системной инфекции.
| Препарат | Дозировка |
| Ампициллин | 45 мг /кг; 7 — 10 дней. |
| Неомицин | 10 мг /кг; 7 дней. |
| Бактериофаг Клебсиелл | От 1 мес. до 6 мес. – 5 мл;
От 6 до 1 года – 10мл; 14 дней. |
| Бифиформ | 1 пакет/ 3 раза в день; 5 – 10 дней. |
Схему лечения, дозировку и необходимые препараты назначает только врач!
При своевременно начатом лечении выздоровление наступает сравнительно быстро. Для предупреждения заболевания необходимо укреплять иммунитет. Именно он является сдерживающим фактором в развитии клебсиеллы.
Победить паразитов можно!
Антипаразитарный комплекс® — Надежное и безопасное избавление от паразитов за 21 день!
- В состав входят только природные компоненты;
- Не вызывает побочных эффектов;
- Абсолютно безопасен;
- Защищает от паразитов печень, сердце, легкие, желудок, кожу;
- Выводит из организма продукты жизнедеятельности паразитов.
- Эффективно уничтожает большую часть видов гельминтов за 21 день.
Сейчас действует льготная программа на бесплатную упаковку. Читать мнение экспертов.
Интересно знать:
Список литературы
- Centers for Disease Controland Prevention. Brucellosis. Parasites. Ссылка
- Corbel M. J. Parasitic diseases // World Health Organization. Ссылка
- Young E. J. Best matches for intestinal parasites // Clinical Infectious Diseases. — 1995. Vol. 21. — P. 283-290. Ссылка
- Ющук Н.Д., Венгеров Ю. А. Инфекционные болезни: учебник. — 2-е издание. — М.: Медицина, 2003. — 544 с.
- Распространенность паразитарных болезней среди населения, 2009 / Коколова Л. М., Решетников А. Д., Платонов Т. А., Верховцева Л. А.
- Гельминты домашних плотоядных Воронежской области, 2011 / Никулин П. И., Ромашов Б. В.
Статья для пациентов с диагностированной доктором болезнью. Не заменяет приём врача и не может использоваться для самодиагностики.
Лучшие истории наших читателей
Тема: Во всех бедах виноваты паразиты!
От кого: Людмила С. (ludmil64@ya.ru)
Кому: Администрации Noparasites.ru
Не так давно мое состояние здоровья ухудшилось. Начала чувствовать постоянную усталость, появились головные боли, лень и какая-то бесконечная апатия. С ЖКТ тоже появились проблемы: вздутие, понос, боли и неприятный запах изо рта.
Думала, что это из-за тяжелой работы и надеялась, что само все пройдет. Но с каждым днем мне становилось все хуже. Врачи тоже ничего толком сказать не могли. Вроде как все в норме, но я-то чувствую, что мой организм не здоров.
Решила обратиться в частную клинику. Тут мне посоветовали на ряду с общими анализами, сдать анализ на паразитов. Так вот в одном из анализов у меня обнаружили паразитов. По словам врачей – это были глисты, которые есть у 90% людей и заражен практически каждый, в большей или меньшей степени.
Мне назначили курс противопаразитных лекарств. Но результатов мне это не дало. Через неделю мне подруга прислала ссылку на одну статью, где какой-то врач паразитолог делился реальными советами по борьбе с паразитами. Эта статья буквально спасла мою жизнь. Я выполнила все советы, что там были и через пару дней мне стало гораздо лучше!
Улучшилось пищеварение, прошли головные боли и появилась та жизненная энергия, которой мне так не хватало. Для надежности, я еще раз сдала анализы и никаких паразитов не обнаружили!
Кто хочет почистить свой организм от паразитов, причем неважно, какие виды этих тварей в вас живут — прочитайте эту статью, уверена на 100% вам поможет! Перейти к статье>>>
Надежное и эффективное средство для борьбы с глистами. Выводит всех паразитов за 21 день.
Как Избавить свой организм от опасных для жизни паразитов, пока не поздно!
Врач паразитолог рассказывает, каке существуют эффективные методы борьбы с гельминтами.
Поиск лекрств от паразитов